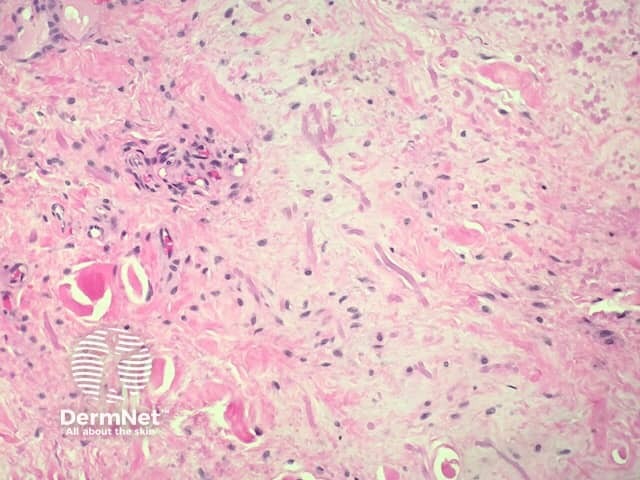
Figure 4

Main menu
Common skin conditions
NEWS
Join DermNet PRO
Read more
Quick links
Lesions (benign) Diagnosis and testing
Author: Adjunct A/Prof Patrick Emanuel, Dermatopathologist, Clínica Ricardo Palma, Lima, Peru. DermNet Editor in Chief: Adjunct A/Prof Amanda Oakley. Copy edited by Maria McGivern/Gus Mitchell. June 2018.
Introduction Histology Special studies Differential diagnoses
Elastofibroma usually presents on the back (usually in the subscapular region) as a poorly defined mass or pseudotumour. It is also called elastofibroma dorsi. Repetitive manual labour is thought to give rise to degeneration of elastic and fibrous tissues.
In elastofibroma, the histopathology shows dense accumulation of eosinophilic tissue irregularly interdigitated into adipose tissue (figure 1). A higher power examination shows collagen bundles that alternate with large, thick eosinophilic elastic fibres (figures 2–4).

Figure 1

Figure 2

Figure 3
Figure 4
Elastic stains can be used to highlight the morphology of the abnormal elastic fibres. The elastic fibres may be fragmented into linear globules, which are described as beads on a string.
Other diagnoses to be considered include: